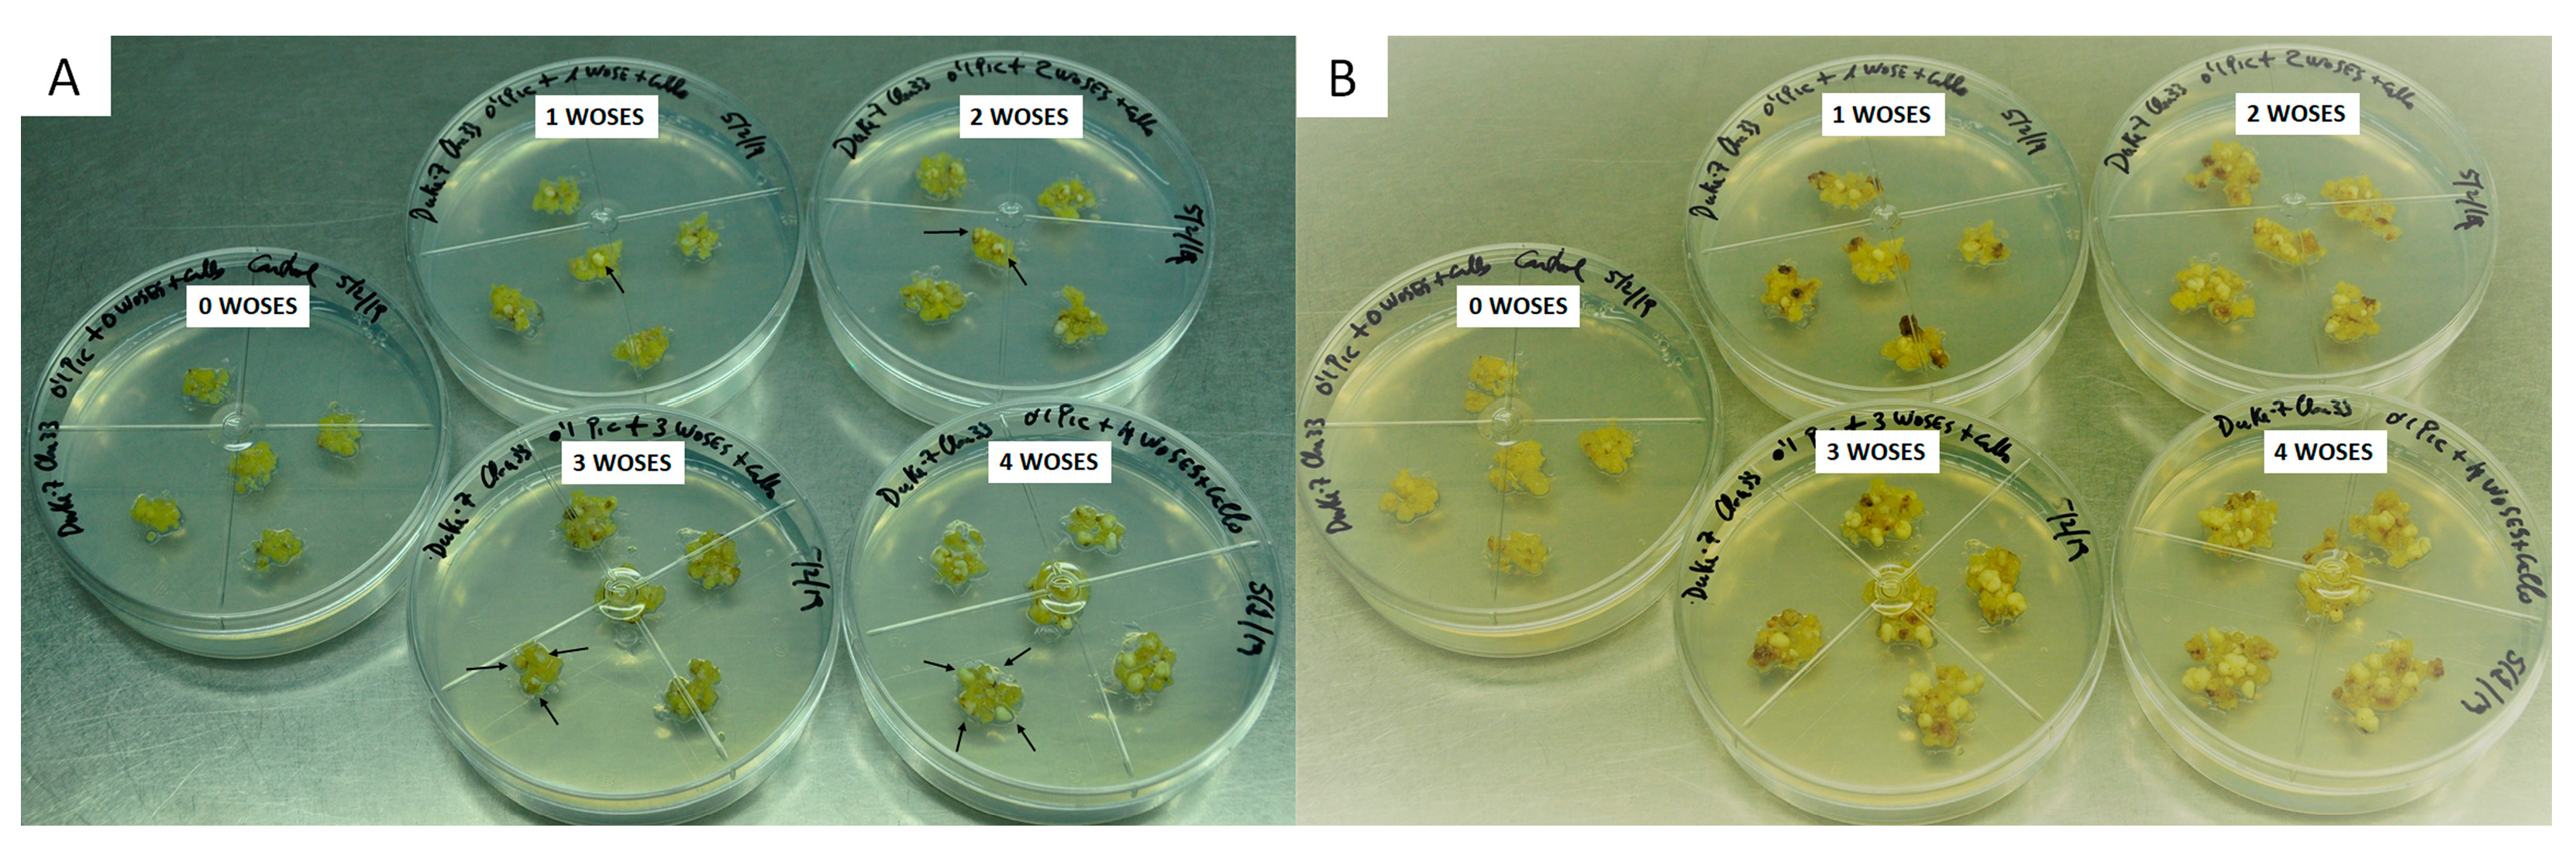
Plants 13 00037 g001
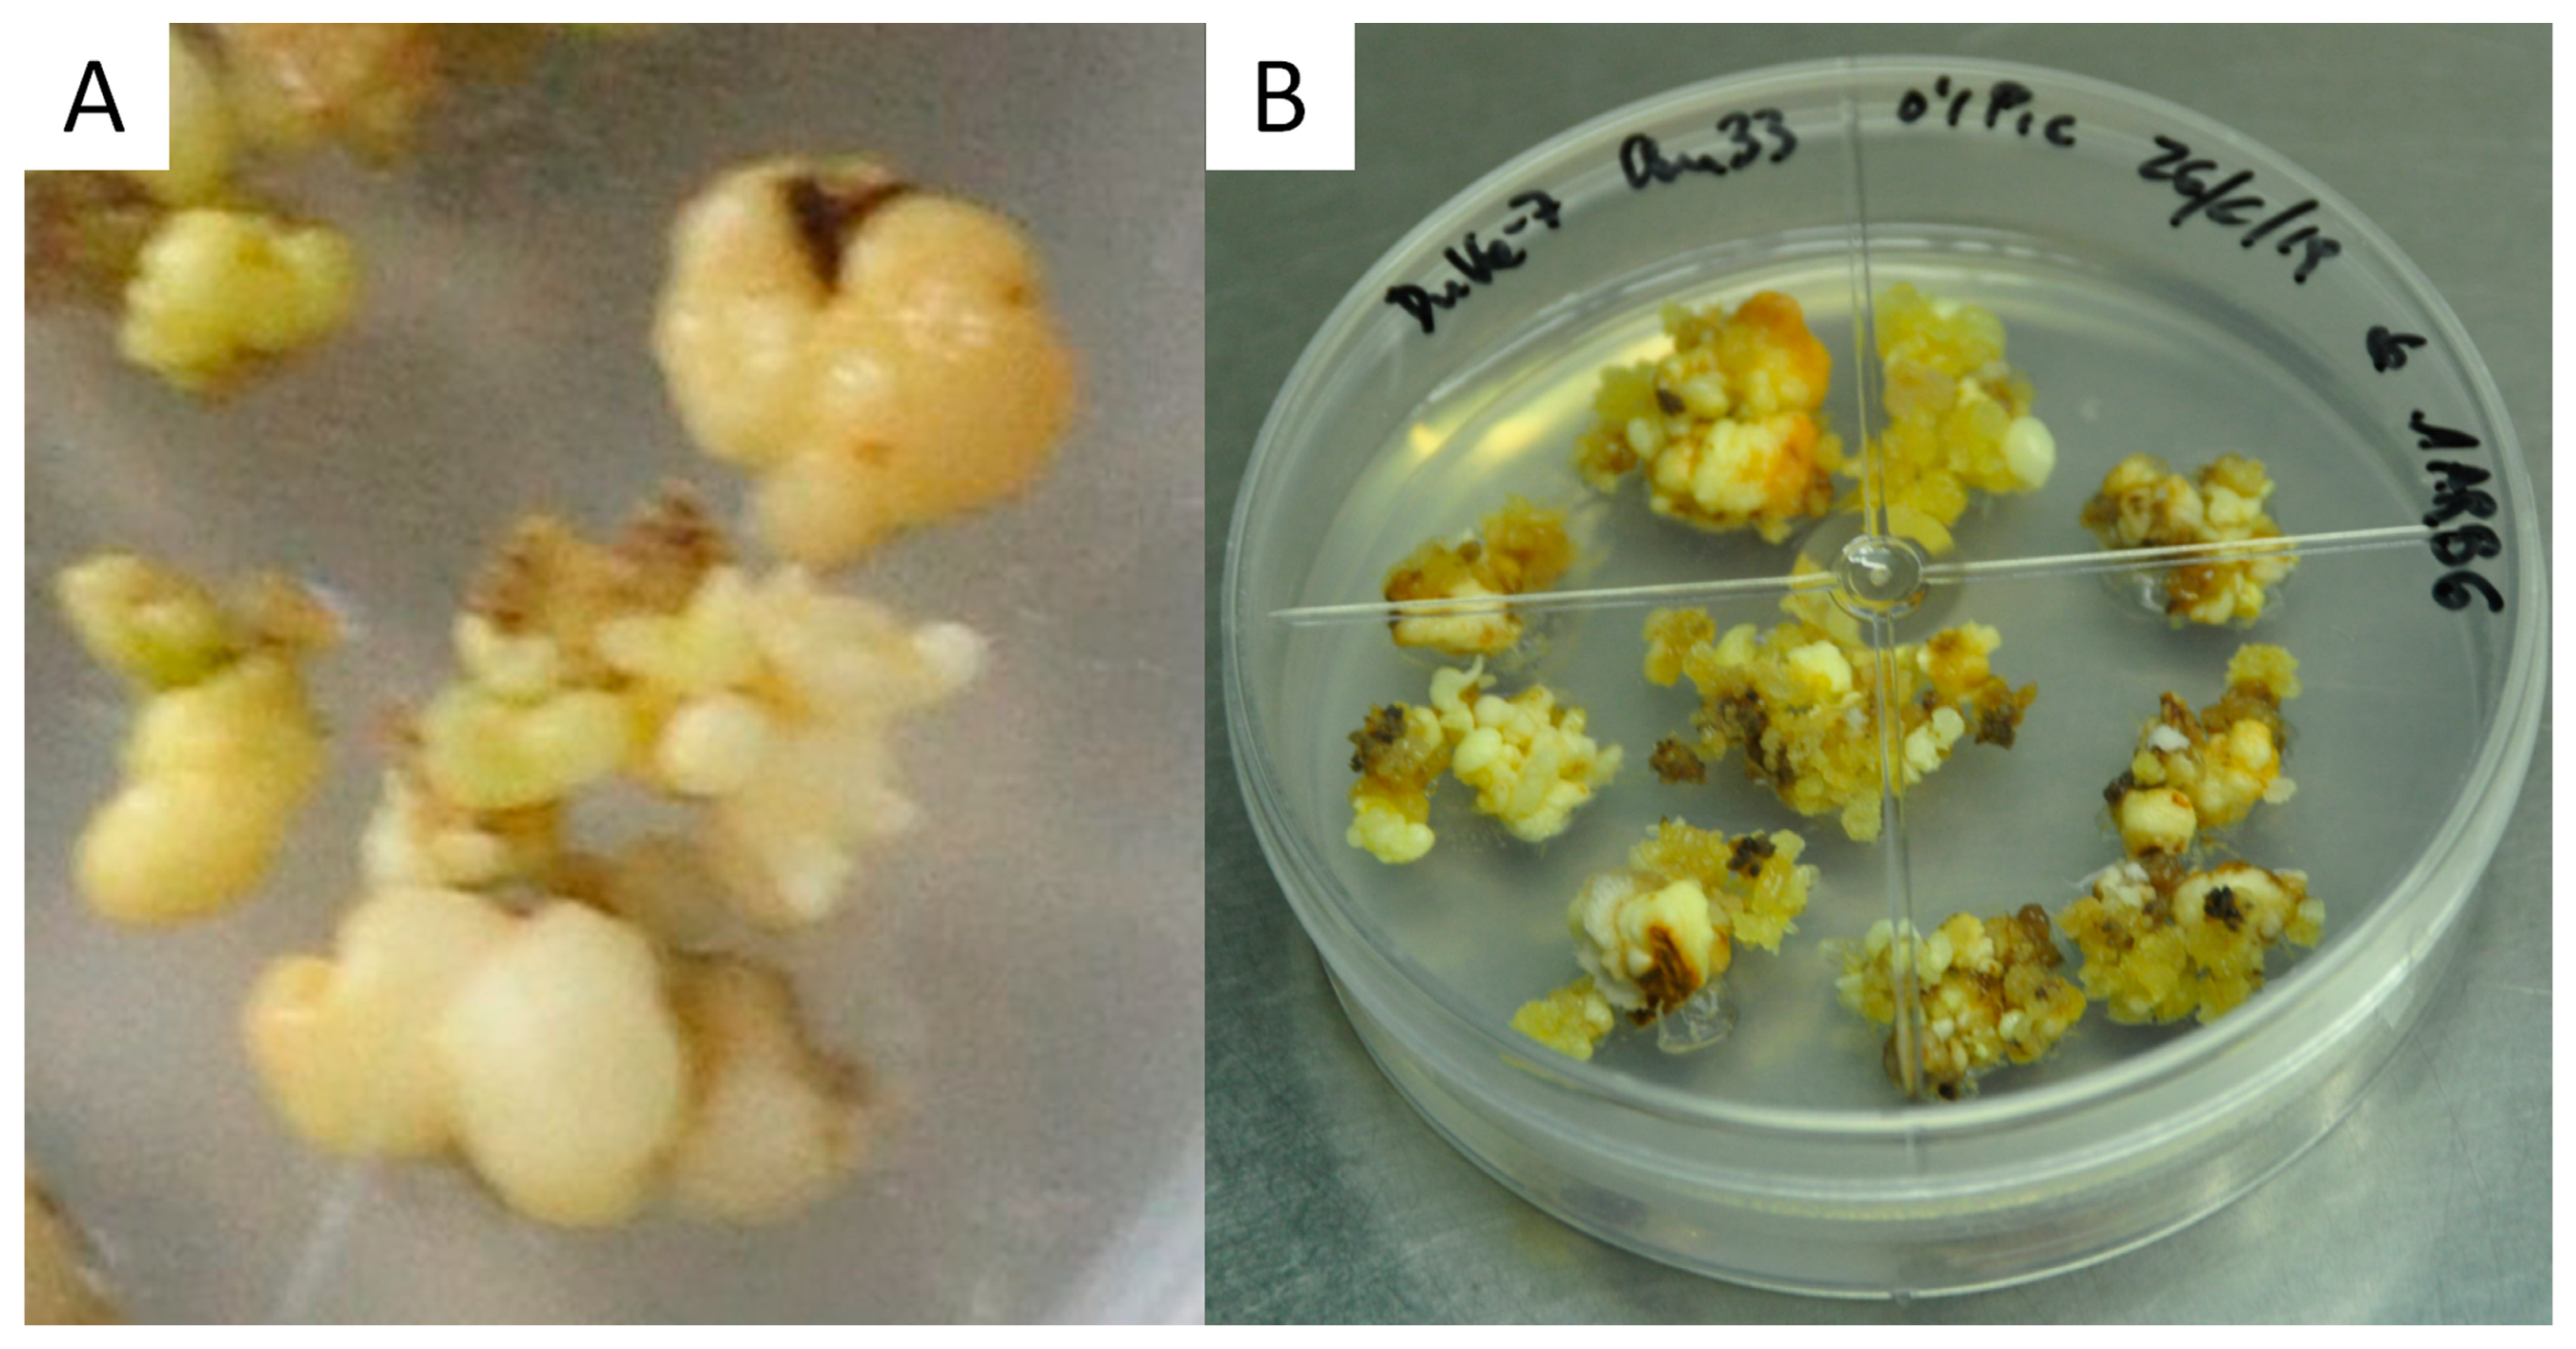
Plants 13 00037 g007

Effect of Arabinogalactans on Induction of White-Opaque Somatic Embryos of Avocado (Persea americana Mill.) cv. Duke-7
Abstract
:1. Introduction
2. Results
2.1. Preliminary WOSE Induction Bioassays
2.2. Isolation and Characterization of AGP
2.3. Isolation and Characterization of AGP WOSE Induction through AGP Supplementation
2.4. WOSE Induction through AGP Plus One WOSE Supplementation
3. Discussion
4. Materials and Methods
4.1. In Vitro Somatic Embryogenesis
4.2. Somatic Embryogenesis Bioassays
4.3. Extraction of AGPs
4.4. AGP Supplementation Assays
4.5. AGP Plus WOSE Supplementation Assays
4.6. Statistical Analysis
5. Conclusions
Supplementary Materials
Author Contributions
Funding
Data Availability Statement
Conflicts of Interest
References
- FAOSTAT. Database 2021 Food and Agricultural Organization, United Nations, Rome. Available online: http://faostat.fao.org/site/340 (accessed on 10 September 2023).
- Newett SD, E.; Crane, J.H.; Balerdi, C.F. Cultivars and rootstocks. In The Avocado. Botany, Production and Uses; Whiley, A.W., Schaffer, B., Wistenholme, B.N., Eds.; CABI Publishing: Wallingford-Oxon UK, 2002; pp. 161–187. [Google Scholar] [CrossRef]
- Marais, L.J. Avocado diseases of major importance worldwide and their management. In Diseases of Fruits and Vegetables; Naqvi, S.A.M.H., Ed.; Springer: Dordrecht, The Netherlands, 2004; Volume 2, pp. 1–36. [Google Scholar]
- Palukaitis, P.; Hatta, T.; Alexander, D.M.; Symons, R.H. Characterization of a viroid associated with avocado sunblotch disease. Virology 1979, 99, 145–151. [Google Scholar] [CrossRef] [PubMed]
- Barcelo-Muñoz, A.; IFAPA—Malaga, Malaga, Spain. Avocado genotypes tolerant to diseases—Personal communication, 2020.
- Cruz-Hernandez, A.; Litz, R.E.; Gomez-Lim, M.; Witjaksono. Agrobacterium tumefaciens mediated mediated transformation of embryogenic avocado cultures and regeneration of somatic embryos. Plant Cell Rep. 1998, 17, 493–503. [Google Scholar] [CrossRef] [PubMed]
- Efendi, D. Transformation and Cryopreservation of Embryogenic Cultures of Avocado (Persea americana Mill.) Cultures. Ph.D. Thesis, University of Florida, Gainesville, FL, USA, 2003. [Google Scholar]
- Raharjo, S.H.T.; Witjaksono Gomez-Lim, M.; Padilla, G.; Litz, R.E. Recovery of avocado (Persea americana Mill.) plants transformed with the antifungal plant defensin gene PDF1.2. In Vitro Cell. Dev. Biol. Plant 2008, 44, 254–262. [Google Scholar] [CrossRef]
- Barceló-Muñoz, A.; Encina, C.L.; Simón-Pérez, E.; Pliego-Alfaro, F. Micropropagation of adult avocado. Plant Cell Tissue Organ Cult. 1999, 58, 11–17. [Google Scholar] [CrossRef]
- Hiti-Bandaralage, J.C.A.; Hayward, A.; Mitter, N. Micropropagation of avocado (Persea americana Mill). Am. J. Plant Sci. 2017, 8, 2898–2921. [Google Scholar] [CrossRef]
- Pliego-Alfaro, F. A Morphogenetic Study of the Avocado (Persea americana Mill.) In Vitro: I. Development of a Rooting Bioassay and Its Application to Studying Restoration by Grafting of Rooting Competence in Adult Shoots. II. Somatic Embryogenesis in Callus. Ph.D. Thesis, University of California, Riverside, CA, USA, 1981. [Google Scholar]
- Mooney, P.A.; Staden, J.V. Induction of embryogenesis in callus from immature embryos of Persea americana. Can. J. Bot. 1987, 65, 622–626. [Google Scholar] [CrossRef]
- Pliego-Alfaro, F.; Murashige, T. Somatic embryogenesis in avocado (Persea americana Mill.) in vitro. Plant Cell Tissue Organ Cult. 1988, 12, 61–66. [Google Scholar] [CrossRef]
- Raviv, A.; Avenido, R.; Tisalona, L.; Damasvo, O.; Mendoza, E.; Pinkas, Y.; Zilkah, S. Callus and somatic embryogenesis of Persea species. Plant Tissue Cult. Biotechnol. 1998, 4, 196–206. [Google Scholar]
- Witjaksono, Y.; Litz, R.E. Induction and growth characteristics of embryogenic avocado cultures. Plant Cell Tissue Organ Cult. 1999, 58, 19–29. [Google Scholar] [CrossRef]
- Witjaksono, Y.; Litz, R.E. Maturation of avocado somatic embryos and plant recovery. Plant Cell Tissue Organ Cult. 1999, 58, 141–148. [Google Scholar] [CrossRef]
- Witjaksono, Y.; Litz, R.E.; Pliego-Alfaro, F. Somatic embryogenesis in avocado (Persea americana Mill.). In Somatic Embryogenesis in Woody Plants; Jain, S.M., Gupta, P.K., Newton, R.J., Eds.; Kluwer Academic: Dordrecht, The Netherlands, 1999; pp. 197–214. [Google Scholar]
- Suarez, I.; Schnell, R.; Kuhn, D.; Litz, R.E. Recovery and indexing of avocado plants (Persea americana) from embryogenic nucellar cultures of an avocado sunblotch viroid-infected tree. Plant Cell Tissue Organ Cult. 2006, 84, 27–37. [Google Scholar] [CrossRef]
- Witjaksono, Y.; Litz, R.E. Effect of gamma irradiation on embryogenic avocado cultures and somatic embryo development. Plant Cell Tissue Organ Cult. 2004, 77, 139–147. [Google Scholar] [CrossRef]
- Avenido, R.A.; Galvez, H.F.; Dimaculangan, J.G.; Welgas, J.L.; Frankie, R.B.; Damasco, O.P. Somatic embryogenesis and embryo culture coupled with gamma irradiation for generating avocado (Persea americana Mill.) mutants in the Philippines. In Technical Report in Induced Mutation in Tropical Fruit Trees; IAEA: Vienna, Austria, 2009; pp. 47–49. Available online: https://www.osti.gov/etdeweb/biblio/22309254 (accessed on 20 July 2022).
- Encina, C.L.; Parisi, A.; O’Brien, C.; Mitter, N. Enhancing somatic embryogenesis in avocado (Persea americana Mill.) using a two-step culture system and including glutamine in the culture medium. Sci. Hortic. 2014, 165, 44–50. [Google Scholar] [CrossRef]
- Palomo-Ríos, E.; Pérez, C.; Mercado, J.A.; Pliego-Alfaro, F. Enhancing frequency of regeneration of somatic embryos of avocado (Persea americana Mill.) using semi-permeable cellulose acetate membranes. Plant Cell Tissue Organ Cult. 2013, 115, 199–207. [Google Scholar] [CrossRef]
- Raharjo, S.H.T.; Litz, R.E. Micrografting and ex vitro grafting for somatic embryo rescue and plant recovery in avocado (Persea americana Mill.). Plant Cell Tissue Organ Cult. 2005, 82, 1–9. [Google Scholar] [CrossRef]
- Perán-Quesada, R.; Sánchez-Romero, C.; Barceló-Muñoz, A.; Pliego-Alfaro, F. Factors affecting maturation of avocado somatic embryos. Sci. Hortic. 2004, 102, 61–73. [Google Scholar] [CrossRef]
- Márquez-Martín, B.; Sesmero, R.; Quesada, M.A.; Pliego-Alfaro, F.; Sánchez-Romero, C. Water relations in culture media influence maturation of avocado somatic embryos. J. Plant Physiol. 2011, 168, 2028–2034. [Google Scholar] [CrossRef]
- Guzmán-García, E.; Sánchez-Romero, C.; Panis, B.; Carpentier, S.C. The use of 2D-DIGE to understand the regeneration of somatic embryos in avocado. Proteomics 2013, 13, 3498–3507. [Google Scholar] [CrossRef]
- Serpe, M.D.; Nothnagel, E.A. Effects of Yariv phenylglycosides on Rosa cell suspensions: Evidence for the involvement of arabinogalactan-proteins in cell proliferation. Planta 1994, 193, 542–550. [Google Scholar] [CrossRef]
- Mollard, A.; Joseleau, J.P. Acacia senegal cells cultured in suspension secrete a hydroxyproline deficient arabinogalactan-protein. Plant Physiol. Biochem. 1994, 32, 703–709. Available online: https://hal.science/hal-00310671 (accessed on 15 July 2022).
- Majewska-Sawka, A.; Nothnagel, E.A. The multiple roles of arabinogalactan proteins in plant development. Plant Physiol. 2000, 122, 3–9. [Google Scholar] [CrossRef] [PubMed]
- Schultz, C.J.; Johnson, K.L.; Currie, G.; Bacic, A. The classical arabinogalactan protein gene family of Arabidopsis. Plant Cell 2000, 12, 1751–1768. [Google Scholar] [CrossRef] [PubMed]
- Van Hengel, A.J.; Roberts, K. AtAGP30, an arabinogalactan-protein in the cell walls of the primary root, plays a role in root regeneration and seed germination. Plant J. 2003, 36, 256–270. [Google Scholar] [CrossRef] [PubMed]
- Borderies, G.; Béchec, M.; Rossignol, M.; Lafitte, C.; Deunff, E.; Beckert, M.; Dumas, C.; Matthys-Rochon, E. Characterization of proteins secreted during maize microspore culture: Arabinogalactan proteins (AGPs) stimulate embryo development. Eur. J. Cell Biol. 2004, 83, 205–212. [Google Scholar] [CrossRef] [PubMed]
- Letarte, J.; Simion, E.; Miner, M.; Kasha, K.J. Arabinogalactans and arabinogalactan-proteins induce embryogenesis in wheat (Triticum aestivum L.) microspore culture. Plant Cell Rep. 2006, 24, 691–698. [Google Scholar] [CrossRef]
- Seifert, G.J.; Roberts, K. The biology of arabinogalactan proteins. Annu. Rev. Plant Biol. 2007, 58, 137–161. [Google Scholar] [CrossRef]
- Webster, J.M.; Oxley, D.; Pettolino, F.; Bacic, A. Characterization of secreted polysaccharides and (glyco) proteins from suspension of Pyrus communis. Phytochemistry 2008, 69, 873–881. [Google Scholar] [CrossRef]
- Showalter, A.M.; Keppler, B.; Lichtenberg, J.; Gu, D.; Welch, L.R. A bioinformatics approach to the identification, classification, and analysis of hydroxyproline-rich glycoproteins. Plant Physiol. 2010, 153, 485–513. [Google Scholar] [CrossRef]
- Su, S.; Higashiyama, T. Arabinogalactan proteins and their sugar chains: Functions in plant reproduction, research methods, and biosynthesis. Plant Reprod. 2018, 31, 67–75. [Google Scholar] [CrossRef]
- Guillen-Bejarano, R.; IG (CSIC), Sevilla, Spain. Chemical compounds—Personal communication, 2020.
- Basu, D.; Tian, L.; Wang, W.; Bobbs, S.; Herock, H.; Travers, A.; Showalter, A.M. A small multigene hydroxyproline-O-galactosyltransferase family functions in arabinogalactan-protein glycosylation, growth and development in Arabidopsis. BMC Plant Biol. 2015, 15, 295. [Google Scholar] [CrossRef]
- Showalter, A.M. Arabinogalactan-proteins: Structure, expression and function. Cell. Mol. Life Sci. 2001, 58, 1399–1417. [Google Scholar] [CrossRef] [PubMed]
- Svetek, J.; Yadav, M.P.; Nothnagel, E.A. Presence of a Glycosyl-phosphatidylinositol Lipid Anchor on Rose Arabinogalactan Proteins. J. Biol. Chem. 1999, 274, 14724–14733. [Google Scholar] [CrossRef] [PubMed]
- Ellis, M.; Egelund, J.; Schultz, C.J.; Bacic, A. Arabinogalactan-Proteins: Key Regulators at the Cell Surface? Plant Physiol. 2010, 153, 403–419. [Google Scholar] [CrossRef] [PubMed]
- Tan, L.; Showalter, A.M.; Egelund, J.; Hernandez-Sanchez, A.; Doblin, M.S.; Bacic, A. Arabinogalactan-proteins and the research challenges for these enigmatic plant cell surface proteoglycans. Front. Plant Sci. 2012, 3, 140. [Google Scholar] [CrossRef] [PubMed]
- Kreuger, M.; Postma, E.; Brouwer, Y.; van Holst, G.J. Somatic embryogenesis of Cyclamen persicum in liquid medium. Physiol. Plant 1995, 94, 605–612. [Google Scholar] [CrossRef]
- Egertsdotter, U.; Von Arnold, S. Importance of arabinogalactan proteins for the development of somatic embryos of Norway spruce (Picea abies). Physiol. Plant 1995, 93, 334–345. [Google Scholar] [CrossRef]
- Van Hengel, A.J.; Tadesse, Z.; Immerzeel, P.; Schols, H.; Van Kammen, A.; DeVries, S.C. N-Acetylglucosamine and glucosamine-containing arabinogalactan proteins control somatic embryogenesis. Plant Physiol. 2001, 125, 1880–1890. [Google Scholar] [CrossRef]
- Van Hengel, A.J.; Van Kammen, A.; De Vries, S.C. A relationship between seed development, arabinogalactan-proteins (AGPs) and the AGP mediated promotion of somatic embryogenesis. Physiol. Plant 2002, 114, 637–644. [Google Scholar] [CrossRef]
- Poon, S.; Heath, R.L.; Clarke, A.E. A Chimeric Arabinogalactan Protein Promotes Somatic Embryogenesis in Cotton Cell Culture. Plant Physiol. 2012, 160, 684–695. [Google Scholar] [CrossRef]
- Johnson, K.L.; Jones, B.J.; Bacic, A.; Schultz, C.J. The Fasciclin-Like Arabinogalactan Proteins of Arabidopsis. A Multigene Family of Putative Cell Adhesion Molecules. Plant Physiol. 2003, 133, 1911–1925. [Google Scholar] [CrossRef]
- Gaspar, Y.; Johnson, K.L.; McKenna, J.A.; Bacic, A.; Schultz, C.J. The complex structures of arabinogalactan-proteins and the journey towards understanding function. Plant Mol. Biol. 2001, 47, 161–176. [Google Scholar] [CrossRef] [PubMed]
- Toribio, M.; Fernandez, C.; Celestino, C.; Martınez, M.T.; San-Jose, M.C.; Vieitez, A.M. Somatic embryogenesis in mature Quercus robur trees. Plant Cell Tissue Organ Cult. 2004, 76, 283–287. [Google Scholar] [CrossRef]
- Kreuger, M.; Van Holst, G.J. Arabinogalactan proteins are essential in somatic embryogenesis of Daucus carota L. Planta 1993, 189, 243–248. [Google Scholar] [CrossRef]
- Kreuger, M.; Van Holst, G.J. Arabinogalactan-protein epitopes in somatic embryogenesis of Daucus carota L. Planta 1995, 197, 135–141. [Google Scholar] [CrossRef]
- Mallon, R.; Martinez, T.; Corredoira, E.; Vieitez, A.M. The positive effect of arabinogalactan on induction of somatic embryogenesis in Quercus bicolor followed by embryo maturation and plant regeneration. Trees-Struct. Funct. 2013, 27, 1285–1296. [Google Scholar] [CrossRef]
- Shu, H.; Xu, L.; Li, Z.; Li, J.; Jin, Z.; Chang, S. Tobacco arabinogalactan protein NtEPc can promote banana (Musa AAA) somatic embryogenesis. Appl. Biochem. Biotechnol. 2014, 174, 2818–2826. [Google Scholar] [CrossRef] [PubMed]
- Murashige, T.; Skoog, F. A revised medium for rapid growth and bioassays with tobacco tissue culture. Physiol. Plant 1962, 15, 473–497. [Google Scholar] [CrossRef]
- Rodríguez, R.; Jiménez, A.; Guillén, R.; Heredia, A.; Fernández-Bolaños, J. Turnover of white asparagus cell wall polysaccharides during postharvest storage. J. Agric. Food Chem. 1999, 47, 4525–4531. [Google Scholar] [CrossRef]
- Ciucanu, J.; Kerek, F. A Simple and Rapid Method for the Permethylation of Carbohydrates. Carbohydr. Res. 1984, 131, 209–217. [Google Scholar] [CrossRef]
- Bradford, M.M. A rapid and sensitive method for the quantitation of microgram quantities of protein utilizing the principle of protein-dye binding. Anal. Biochem. 1976, 72, 248–254. [Google Scholar] [CrossRef]
- Alaiz, M.; Navarro, J.L.; Giron, J.; Vioque, E. Amino acid analysis by high-performance liquid chromatography after derivatization with diethyl ethoxymethylenemalonate. J. Chromatogr. A 1992, 591, 181–186. [Google Scholar] [CrossRef] [PubMed]

| Glycosyl Composition (%) | Total Sugars (µg mL−1) | Proteins (Bradford) (µg mL−1) | |||||||
|---|---|---|---|---|---|---|---|---|---|
| Rha | Fuc | Ara | Xyl | Man | Gal | Glc | |||
| EC + WS | 18 | 2 | 26 | 3 | 3 | 48 | 1 | 181.5 ± 0.8 a | 38.6 ± 9.0 a |
| EC + WM | 18 | 2 | 27 | 3 | 2 | 49 | 1 | 266.3 ± 1.5 b | 72.5 ± 6.0 b |
| EC + WB | 15 | 2 | 26 | 3 | 1 | 50 | 3 | 274.6 ± 0.7 b | 101.9 ± 12.2 c |
| WM | 16 | 2 | 23 | 3 | 4 | 46 | 7 | 44.9 ± 1.5 c | 44.6 ± 8.0 a |
| EC | 14 | 2 | 23 | 3 | 4 | 45 | 10 | 98.4 ± 5.3 d | 112.3 ± 13.0 c |
| PMAA Derivative | Deduced Linkage | %mol |
|---|---|---|
| 1,5-Di-O-acetyl-1-deuterio-6-deoxy-2,3,4-tri-O-methyl-L-mannitol | T-Rham | 10 |
| 1,4-Di-O-acetyl-1-deuterio-2,3,5-tri-O-methyl-D-arabinitol | T-Araf | 18 |
| 1,5-Di-O-acetyl-1-deuterio-2,3,4-tri-O-methyl-D-arabinitol | T-Arap | 3 |
| 1,3,4-Tri-O-acetyl-1-deuterio-2,5-di-O-methyl-D-arabinitol | 3-Araf | 6 |
| 1,4,5-Tri-O-acetyl-1-deuterio-2,3-di-O-methyl-D-arabinitol | 4-Arap | 3 |
| 1,3,5-Tri-O-acetyl-1-deuterio-2,4,6-tri-O-methyl-D-galactitol | 3-Galp | 15 |
| 1,5,6-Tri-O-acetyl-1-deuterio-2,3,4-tri-O-methyl-D-galactitol | 6-Galp | 9 |
| 1,4,5,6-Tetra-O-acetyl-1-deuterio-2,3-di-O-methyl-D-galactitol | 4,6-Galp | 4 |
| 1,3,5,6-Tetra-O-acetyl-1-deuterio-2,4-di-O-methyl-D-galactitol | 3,6-Galp | 30 |
| 1,3,4,5,6-Penta-O-acetyl-1-deuterio-2-O-methyl-D-galactitol | 3,4,6-Galp | 3 |
| Amino Acid | Concentration (µg mg−1) | % |
|---|---|---|
| Aspartic A. | 22.4 ± 1.2 a | 11 |
| Glutamic A. | 21.9 ± 2.1 a | 11 |
| Hydroxyproline | 52.9 ± 2.4 b | 26 |
| Serine | 10.0 ± 0.8 c | 5 |
| Glycine | 14.8 ± 1.7 d | 7 |
| Threonine | 6.4 ± 0.5 e | 3 |
| Arginine | 10.7 ± 1.8 c | 5 |
| Alanine | 15.3 ± 1.3 d | 8 |
| Valine | 2.9 ± 0.8 f | 1 |
| Methionine | 19.7 ± 0.4 a | 10 |
| Cystine | 2.8 ± 0.4 f | 1 |
| Leucine | 8.6 ± 0.7 e | 4 |
| Phenylalanine | 5.3 ± 0.6 e | 3 |
| Lysine | 8.1 ± 0.5 e | 4 |
| Total | 201.6 ± 13.2 | 100 |
| Concentration of AGP (mg L−1) | Callus Size (0–5) | No. of New WOSEs per Callus | Callus with WOSEs % | Necrosis % | Good Aspect Explants % |
|---|---|---|---|---|---|
| 0 | 2.3 ± 0.6 b | 0.16 ± 0.1 c | 16 ± 5 c | 32 ± 2 a | 92 ± 4 ab |
| 0.5 | 1.9 ± 0.7 c | 0.22 ± 0.1 c | 22 ± 6 c | 18 ± 2 c | 96 ± 3 a |
| 1 | 2.9 ± 0.5 a | 1.70 ± 0.2 a | 84 ± 5 a | 14 ± 1 c | 98 ± 2 b |
| 2 | 2.1 ± 0.5 bc | 1.52 ± 0.2 ab | 80 ± 6 a | 23 ± 1 b | 96 ± 3 a |
| 3 | 2.9 ± 0.5 a | 1.04 ± 0.1 b | 68 ± 7 ab | 29 ± 1 ab | 96 ± 3 a |
| 4 | 2.8 ± 0.5 a | 1.06 ± 0.2 b | 58 ± 7 b | 33 ± 1 a | 82 ± 5 b |
| No. of WOSEs Added Per Callus Explant | Callus Size (0–5) | No. of New WOSEs Per Explant | Callus with WOSEs % | Necrosis % | Good Aspect Explants % |
|---|---|---|---|---|---|
| 0 WOSEs | 2.8 ± 0.7 a | 1.44 ± 0.1 ab | 84 ± 5 a | 19 ± 1 a | 96 ± 3 a |
| 1 small WOSE | 1.8 ± 0.5 b | 1.42 ± 0.2 b | 70 ± 7 a | 11 ± 0 b | 100 ± 0 a |
| 1 medium WOSE | 1.8 ± 0.5 b | 2.02 ± 0.2 a | 72 ± 6 a | 20 ± 0 a | 100 ± 0 a |
| No. of WOSEs Added Per Explant | Callus Size (0–5) | No. of New WOSEs Per Explant | Callus with WOSEs % | Necrosis % | Good Aspect Explants % |
|---|---|---|---|---|---|
| Callus + 0 WOSEs | 2.8 ± 0.7 a | 1.4 ± 0.1 b | 84 ± 5 a | 19 ± 1 a | 96 ± 3 a |
| 3 small WOSEs | 1.2 ± 0.4 c | 1.7 ± 0.2 b | 74 ± 6 a | 22 ± 1 a | 94 ± 3 a |
| 3 medium WOSEs | 1.8 ± 0.4 b | 2.4 ± 0.3 a | 72 ± 6 a | 21 ± 1 a | 96 ± 3 a |
Disclaimer/Publisher’s Note: The statements, opinions and data contained in all publications are solely those of the individual author(s) and contributor(s) and not of MDPI and/or the editor(s). MDPI and/or the editor(s) disclaim responsibility for any injury to people or property resulting from any ideas, methods, instructions or products referred to in the content. |
© 2023 by the authors. Licensee MDPI, Basel, Switzerland. This article is an open access article distributed under the terms and conditions of the Creative Commons Attribution (CC BY) license (https://creativecommons.org/licenses/by/4.0/).
Share and Cite
Encina, C.L.; Hamdi, A.; Rodríguez-Arcos, R.; Jiménez-Araujo, A.; Regalado, J.J.; Guillén-Bejarano, R. Effect of Arabinogalactans on Induction of White-Opaque Somatic Embryos of Avocado (Persea americana Mill.) cv. Duke-7. Plants 2024, 13, 37. https://doi.org/10.3390/plants13010037
Encina CL, Hamdi A, Rodríguez-Arcos R, Jiménez-Araujo A, Regalado JJ, Guillén-Bejarano R. Effect of Arabinogalactans on Induction of White-Opaque Somatic Embryos of Avocado (Persea americana Mill.) cv. Duke-7. Plants. 2024; 13(1):37. https://doi.org/10.3390/plants13010037
Chicago/Turabian StyleEncina, C. L., A. Hamdi, R. Rodríguez-Arcos, A. Jiménez-Araujo, J. J. Regalado, and R. Guillén-Bejarano. 2024. "Effect of Arabinogalactans on Induction of White-Opaque Somatic Embryos of Avocado (Persea americana Mill.) cv. Duke-7" Plants 13, no. 1: 37. https://doi.org/10.3390/plants13010037
APA StyleEncina, C. L., Hamdi, A., Rodríguez-Arcos, R., Jiménez-Araujo, A., Regalado, J. J., & Guillén-Bejarano, R. (2024). Effect of Arabinogalactans on Induction of White-Opaque Somatic Embryos of Avocado (Persea americana Mill.) cv. Duke-7. Plants, 13(1), 37. https://doi.org/10.3390/plants13010037

